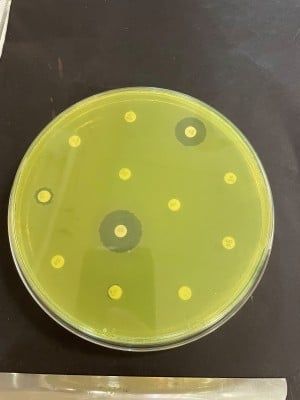

Antimicrobial resistance #AMR
@antimicrobial.bsky.social
15K followers
14K following
370 posts
AMR Antimicrobial Resistance
Fernanda C. Petersen,
Professor, University of Oslo and
Ulf R. Dahle,
Specialist Director,
Norwegian Institute of Public Health
Posts
Media
Videos
Starter Packs
Reposted by Antimicrobial resistance #AMR
Reposted by Antimicrobial resistance #AMR
Reposted by Antimicrobial resistance #AMR
Reposted by Antimicrobial resistance #AMR
Reposted by Antimicrobial resistance #AMR
Reposted by Antimicrobial resistance #AMR
Reposted by Antimicrobial resistance #AMR
Ulf R. Dahle
@ulfdahle.bsky.social
· Sep 4

Florida plans to become first state to eliminate all childhood vaccine mandates
Florida plans to become the first state to eliminate vaccine mandates that have been a cornerstone of public health policy for decades in keeping schoolchildren and citizens safe from infectious disea...
www.washingtonpost.com
Reposted by Antimicrobial resistance #AMR